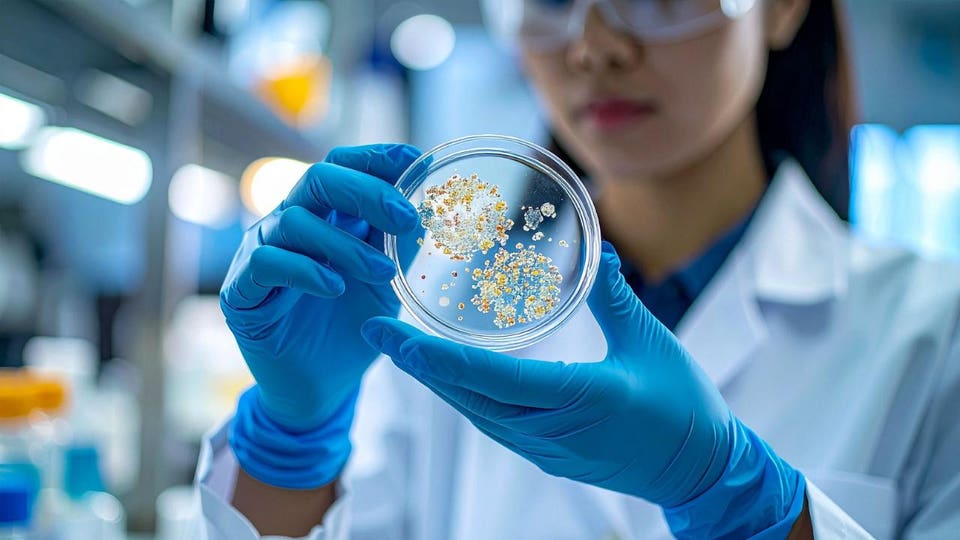
0x0.jpg

A Knight of the Seven Kingdoms just managed to pass up Game of Thrones and House of the Dragon and set a Rotten Tomatoes franchise record.
Submissions Open for 3M’s Nationwide Middle School Science Competition
Finalists will receive one-to-one mentorship with a 3M scientist, national recognition, and a chance to win top prize: $25,000 and title of “America’s Top Young Scientist”
St. Paul, Minn. and Charlotte, NC. (Jan. 21, 2026) – 3M (@3M) and Discovery Education today announced that the 2026 3M Young Scientist Challenge (#YoungScientist) is now open to entries. The annual 3M Young Scientist Challenge is the nation’s premier middle school science competition.
“Every year, the 3M Young Scientist Challenge showcases what’s possible when students combine imagination with scientific thinking,” said Dr. John Banovetz, chief technology officer, 3M. “We’re proud to support a program that helps young learners gain confidence, explore new possibilities, and imagine a brighter future.”
Challenge details
- The 3M Young Scientist Challenge invites students in grades 5-8 to use science to solve everyday problems and improve the world around them.
- Students compete for an exclusive mentorship with a 3M scientist, a $25,000 grand prize, and the chance to earn the title of “America’s Top Young Scientist.”
- The contest will name 10 finalists, four honorable mentions, and up to 51state merit winners nationwide and in Washington, D.C.
- Competition entries are accepted at YoungScientistLab.com until the deadline on April 30, 2026.
How to enter
- To enter, students in grades 5-8 submit a brief video explaining their original idea to solve an everyday problem using science.
- Submissions are evaluated for their communication skills, creativity, and scientific knowledge.
- Categories include robotics, home improvement, automotive, safety, AR/VR, and climate technology.
Next steps
- Mentorship: In June 2026, 10 finalists will be chosen to participate in an exclusive summer mentorship program, during which they will work closely with and learn from a 3M scientist.
- Final event: Each finalist will then compete in the final event at the 3M Innovation Center in St. Paul, Minnesota, Oct. 12-14, 2026. This event will include hands-on challenges, presentations, live judging, and the grand prize winner announcement.
Previous winners
- Previous challenge finalists and 3M scientists have collaborated to create solutions for a wide variety of real-world problems, including food safety, cybersecurity, coral reef health, water conservation, alternative energy sources, energy consumption, air pollution, transportation efficiency, and many more.
- The 2025 winner – 13-year-old Kevin Tang from Hacienda Heights, California – created a novel fall detection device that can accelerate emergency responses to falls among older adults at home, even in the dark. Kevin created an algorithm that analyzes video input to identify falls and triggers alerts to loved ones via a smart phone application. His new solution advances current offerings on the market through the ability to capture imagery at night and provide around-the-clock monitoring. The device can also detect irregular movements while the individual is walking, which could be a symptom of a stroke.
Now in its 19th year, the 3M Young Scientist Challengecontinues to inspire and challenge middle school students to think creatively and apply the power of STEM to discover real-world solutions. America’s Top Young Scientists have given TED Talks, filed patents, founded nonprofits, made the Forbes 30 Under 30 list, and exhibited at the White House Science Fair. These young innovators have also been named TIME Magazine’s first Kid of the Year, featured in The New York Times Magazine, Forbes, and Business Insider, and appeared on national television programs such as Good Morning America, The Kelly Clarkson Show, and more. In addition, a 3M Young Scientist Challenge Alumni Network was formed in fall 2022 and includes more than 100 former challenge finalists, winners, and mentors who take part in networking opportunities and more.
“All across the United States are powerful young minds with incredible ideas. The 3M Young Scientist Challenge offers middle school students an unparalleled opportunity to turn creative ideas into world-changing solutions,” said Catherine Dunlop, senior vice president of corporate partnerships at Discovery Education. “With a blend of innovation, mentorship, hands-on learning, and creation, this challenge offers students a unique opportunity to deepen science skills and make an impact on everyday lives.”
To learn more about the 3M Young Scientist Challenge, including entry details, and to find supporting resources, visit YoungScientistLab.com.
###
About 3M
3M (NYSE: MMM) is focused on transforming industries around the world by applying science and creating innovative, customer-focused solutions. Our multi-disciplinary team is working to solve tough customer problems by leveraging diverse technology platforms, differentiated capabilities, global footprint, and operational excellence. Discover how 3M is shaping the future at 3M.com/news.
About Discovery Education
Discovery Education is the worldwide edtech leader whose state-of-the-art, PreK-12 digital solutions help educators engage all students and support academic achievement. Through award-winning multimedia content, instructional supports, and innovative classroom tools that are effective, engaging, and easy to use, Discovery Education enables educators to deliver powerful learning experiences in 45% of U.S. K-12 schools and across 100+ countries and territories. Through partnerships with districts, states, and trusted organizations, Discovery Education empowers teachers with essential solutions that inspire curiosity, build confidence, and accelerate learning. Learn more at www.discoveryeducation.com.
Contact
Email: 3MNews@mmm.com
Grace Maliska
Discovery Education
Email: gmaliska@discoveryed.com
The post Submissions Open for 3M’s Nationwide Middle School Science Competition appeared first on Discovery Education.
Shure’s New KSM Premium Mics With True-To-Life Audio And Ultra-Low Self-Noise At NAMM
Shure has been around for 100 years and today it unveils the new KSM series of condenser microphones at NAMM, the trade show for the music and recording industries.
The 10 Most Watched Netflix Shows Of 2025 Part 2, With One Big Surprise
Here are the most watched TV shows on Netflix in the second half of 2025, where one big surprise stands out on the list.
4 Ways To Replace Your Over-Explaining Habit, By A Psychologist
Overexplaining is not a personality defect. It is a learned habit of ensuring one’s safety when the world appears unpredictable.
How China Became the Biotech Industry’s Back-Office
China quietly became biotech’s back-office, from molecule synthesis and clinical trials to novel drug licensing. Now the industry—and Washington—are rethinking the risks.
Meet Dracaena — The Tree That Seeps With Bright Red ‘Dragon’s Blood’
The story of dragon’s blood spans folklore, botany and biochemistry. Here’s how it teaches us how trees respond to injury with blood-red resilience.
TerraMaster Launches D1 SSD Pro Thunderbolt 5 Compatible SSD Enclosure Without Fans
The D1 SSD Pro is an 80Gbps Thunderbolt 5-compatible M.2 NVMe enclosure for professional creators, Mac power users and anyone working with high-performance workflows.
Forget Virtual Land. The Metaverse’s New Currency Is Data
The metaverse is far from dead. It is evolving into something more interesting and, ultimately, more valuable, as a source of data gathering to power AI models.
Free Professional Development from IBM SkillsBuild and Discovery Education Equips High School Educators With AI, Cybersecurity, and Digital Literacy Skills
Charlotte, NC (Wednesday, January 21, 2026) — High school educators now have access to free professional development credential courses focused on AI, cybersecurity, and digital literacy through IBM SkillsBuild, IBM’s free global technology education program. Through the IBM and Discovery Education collaboration, educators gain free access to practical, workforce-aligned learning experiences and industry-recognized credentials designed to support instruction in emerging technologies. Over the next two years, the initiative is expected to reach up to 100,000 high school educators through Discovery Education’s professional learning network, with content structured to integrate seamlessly into existing professional development programs.
Research from the Education Insights Report 2025-2026 reveals that only about half (53%) of teachers are optimistic about AI’s potential to support teaching and learning due to lack of clear guidance and professional development. Drawing on IBM’s leadership in technology and workforce development, IBM SkillsBuild offers accessible learning pathways that combine interactive content, real-world applications, and credentials. These pathways enable educators to strengthen their understanding of AI and related technologies while building confidence in applying them in the classroom.
Through this collaboration, educators teaching grades 9-12 will gain access to:
- Free, self-paced learning modules in AI, cybersecurity, and digital literacy, all intentionally designed to fit into busy schedules.
- Industry‑recognized credentials from Credly and documentable professional development hours.
- Classroom-ready lesson plans grounded in real‑world applications and aligned to educator needs across an array of disciplines.
“IBM SkillsBuild is central to IBM’s commitment to skill 30 million people worldwide by 2030,” said Lydia Logan, Vice President, Global Education and Workforce Development at IBM. “Educators play a critical role in preparing students for the future of work. Through this collaboration with Discovery Education, we’re helping teachers build practical, workforce-aligned skills in AI, cybersecurity, and digital literacy that can translate directly into classroom instruction and expanded opportunity for students.”
The collaboration leverages Discovery Education’s trusted reach and professional learning expertise to help scale access to IBM SkillsBuild across the K–12 ecosystem, expanding opportunities for educators to engage with high-quality, relevant professional development and credentials.
“Emerging technologies, such as AI, have the potential to support educators in delivering excellent instruction with long-lasting impact for students” said Catherine Dunlop, Senior Vice President of Corporate Partnerships at Discovery Education. “Educators need and want guidance, and that’s why this collaboration offers educators industry‑recognized credentials and practical insights. Together with IBM, we are creating a powerful bridge for educators between transformative technologies and the daily realities of K-12 instruction.”
To access the IBM SkillsBuild professional development content, please visit skillsbuild.org.
###
About Discovery Education
Discovery Education is the worldwide edtech leader whose state-of-the-art, PreK-12 digital solutions help educators engage all students and support academic achievement. Through award-winning multimedia content, instructional supports, and innovative classroom tools that are effective, engaging, and easy to use, Discovery Education enables educators to deliver powerful learning experiences in 45% of U.S. K-12 schools and across 100+ countries and territories. Through partnerships with districts, states, and trusted organizations, Discovery Education empowers teachers with essential solutions that inspire curiosity, build confidence, and accelerate learning. Learn more at www.discoveryeducation.com.
Contact
Joseph Brown
IBM
Email: Joseph.Brown4@ibm.com
Grace Maliska
Discovery Education
Email: gmaliska@discoveryed.com
The post Free Professional Development from IBM SkillsBuild and Discovery Education Equips High School Educators With AI, Cybersecurity, and Digital Literacy Skills appeared first on Discovery Education.